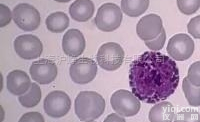
OP9<em>小鼠</em>基质细胞,<em>小鼠</em><em>细胞系</em>

PK136细胞:小鼠B淋巴瘤X小鼠瘤细胞系 细胞专注复苏培养
细胞来源说明:细胞主要来源ATCC、DSMZ、ECACC、RIKEN、INCell、promocell、ScienCell、ECACC、JCRB、KCLB、Asterand、ICLC以及少数国外大学建系
细胞常规培养传代流程(请严格遵照无菌操作):1)吸出原培养瓶中的培养基,PBS缓冲液润洗细胞两次,加2-3ml 0.25%胰酶进行消化细胞(注意把握消化时间,通常控制在1-2min);2)镜下观察消化情况,在细胞边缘缩小,贴壁松动时(不建议消化到细胞漂浮)去掉胰酶,加6-8ml完全培养基,轻轻吹打细胞层,尽量把细胞层吹落,吹散;3)取部分细胞悬液转移到新的培养皿/瓶中,添加适当的完全培养基,把细胞悬液打匀,于培养箱中培养;4)注意培养基PH值变化情况,定期换液(每周2-3次),待细胞密度达到80%以后重复1项操作或者冻存;特别注意:(如使用公共实验室或者初次接触细胞培养,建议添加双抗培养)1)收到细胞后请尽快更换为含15%血清的新鲜培养基,如因特殊情况需要继续使用原瓶,请在原瓶培养基中额外添加10%的血清,(原瓶培养基的继续使用时间Z长不宜超过72小时);2)贴壁细胞收到当天切忌立刻消化,请将细胞换液后放置培养箱孵育到第二天再做消化传代,请优先选择直径6cm的培养皿进行传代培养;3)如签收时出现培养瓶壁破裂,漏液等情况请及时做好照片记录并联系实验室。
PK136细胞:小鼠B淋巴瘤X小鼠瘤细胞系 细胞专注复苏培养
细胞生长特性:贴壁或悬浮,详见细胞说明书部分
细胞物种来源:人源或鼠源等其它物种来源
细胞形态特性:详见细胞说明书
【细胞培养中细菌、霉菌的污染情况总结】细菌:细菌在普通倒置显微镜下为黑色细沙状,根据感染细菌的不同,可有不同的外形,培养液一般会浑浊变黄,对细胞生长影响明显。仔细检查一下器皿的灭菌情况,是否在高压灭菌时放气时间足够,压力足够!尤其是和储存培养液接触的移液管等物品,连续两次污染的话有可能造成储存液污染,一定要注意!下次使用前检查一下培养液是否存在浑浊的现象!可在培养液中加相应的抗生素处理;霉菌:培养液是清亮的,倒置显微镜下无杂质,37度孵箱培养2-3天,仍清亮,但出现絮状杂质,镜下可见呈细丝状的团状漂浮物,可看到明显的菌丝,细胞仍可生长,但时间长之后,细胞的活力状态变差,用硫酸铜溶液擦拭CO2孵箱内,再把水盘里也加上饱和量的硫酸铜。或者在培养箱的托盘加入饱和的消毒磷酸氢二钠高盐液体,可以防止霉菌污染。CO2孵箱被霉菌污染后,可把所有细胞暂时转移,采用擦洗孵箱(包括隔板,箱壁)。并把放置在孵箱内一个小时,使其蒸汽弥漫。待的气味消散后,再移入细胞。孵箱应定期清洁(2月左右),尤其在多雨的季节。其它培养箱清洗方法是:用84液擦洗-清水擦洗-75%酒精擦洗-紫外灯照。预防霉菌污染,可在培养基里加3u/ml的两性霉素或制霉菌素或D或双抗;但细胞一旦污染,很难挽救,制霉菌素或D或双抗都于事无补,建议舍弃该污染细胞,将环境彻底消毒,如果所有细胞都污染,可能是系统污染,检查一下培养基和器材,如果只是个别污染,可能是操作问题,就要注意操作。
细胞产品包装:复苏形式:T25培养瓶(一瓶)或冻存形式:1ml冻存管(两支)
PK136细胞:小鼠B淋巴瘤X小鼠瘤细胞系 细胞专注复苏培养
细胞背景资料:详见相关文献介绍
传代细胞培养注意事项:1)掌握好细胞消化的时间,消化时间过短时,细胞不宜从瓶壁脱落,过长的消化会导致细胞脱落、损伤;2)掌握好消化浓度,当消化液浓度过高时,消化时间应缩短,过低时细胞消化时间相对延长。体内细胞培养及其操作步骤:瘤细胞悬液接种1)无菌选取生长良好(有光泽,淡红色)瘤组织或对数生长期培养瘤细胞;2)在PBS中将瘤组织剪碎后用匀浆器研磨,经80~100目筛网过滤成细胞悬液;3)培养细胞应用PBS洗两遍;4)计数并调整细胞浓度至10(7)~10(8)/ml;5)常规消毒后,于接种部位(通常为背部或腋窝腹股沟皮下)用医用注射器皮下潜行一段后注入细胞悬液(0.1ml/部位,>10(6)细胞)。初次接种成功率低,细胞数尽可能多一些;6)次日注意观察动物一般情况。初次接种一般有一段较长的潜伏期,以后随着传代潜伏期逐渐缩短,固定为一个相对稳定的时间。腹水瘤的建立与腹水瘤的接种:将实体瘤细胞直接种于小鼠腹腔、腹壁或其他部位,引起腹水,腹水中含有瘤细胞,将这种腹水反复传代,即可成为腹水瘤。初次传代时,腹水常呈血性(含大量红细胞),反复传代后腹水逐渐变成乳白色。腹水瘤的接种过程如下:1)将冻存或培养的腹水瘤细胞离心和洗涤,进行细胞计数;2)消毒动物,左下腹穿刺接种1×10(6)腹水瘤细胞;3)接种腹水瘤细胞后约7-12d,待小鼠腹部明显膨大。用碘酒棉球消毒小鼠腹部,用9号针头抽取腹水,也可行腹部解剖后,用滴管吸取。每只小鼠可抽3-5ml;4)抽取的腹水经3000rpm离心15min,收集上清,分装冻存备用。
PK136细胞:小鼠B淋巴瘤X小鼠瘤细胞系 细胞专注复苏培养
细胞传代方法:1:2-1:3传代;每周换液2-3次。
SW 900细胞系(人肺癌细胞冷藏平台)
G401细胞系(人肾癌Wilms细胞冷藏平台)
PC-12[PC12]细胞系(大鼠肾上腺嗜铬细胞冷藏平台)
DL-sec-Phenethyl alcohol
(±)-α-Bisabolol
4-Hydroxyisophthalic Acid
Bis((5-fluoropyridin-3-yl)Methyl)aMine
2-BroMo-6-chloro-4-(trifluoroMethyl)aniline, 97%
NCI-H2073[H2073]细胞系(人肺癌细胞冷藏平台)
SK-HEL-1细胞系(人皮肤黑色素瘤细胞冷藏平台)
SU-DHL-4细胞系(人B淋巴瘤细胞冷藏平台)
SW-13细胞系(人肾上腺皮质癌细胞冷藏平台)
3T3-Swiss albino细胞系(小鼠胚胎成纤维细胞冷藏平台)
3T3-Swiss albino细胞系(小鼠胚胎成纤维细胞冷藏平台)
ATN-1细胞系(人T淋巴细胞冷藏平台)
2,5-Dichlorobenzyl chloride
Phenol, 2-[[(4-methylphenyl)amino]methyl]-
2,2'-Dithiobis(pyridine-N-oxide)
2-Amino-6-chloro-4-pyrimidinol
6-Chloro-2-methyl-3-nitropyridine
HCC-1833细胞系(人肺癌腺癌细胞冷藏平台)
Capan-1细胞系(人癌细胞冷藏平台)
BEP2D细胞系(人永生化支气管上皮细胞冷藏平台)
NCL-H460细胞系(人肺癌细胞冷藏平台)
NCI-H2110细胞系(人肺癌细胞冷藏平台)
CTLL-2细胞系(小鼠T淋巴细胞冷藏平台)
hRPE细胞系(人视网膜色素上皮细胞冷藏平台)
H08910细胞系(人卵巢癌细胞冷藏平台)
RINm5f细胞系(大鼠胰岛β细胞冷藏平台)
Kuffer细胞系(人肝枯否细胞冷藏平台)
NCI-H889[H889]细胞系(人肺癌细胞冷藏平台)
3,7-Diaza-1,9-NonanediaMine
2,2,3,3,4,4,4-Heptafluorobutyl Methacrylate, 97%, stab. with 20-50 ppM hydroquinone
2,4,6-TriMethylbenzoic acid, 99%
IsorhaMnetin-3-O-nehesperidine
SodiuM Tanshinone IIA Silate
HCC-1395细胞系(人乳腺癌细胞冷藏平台)
KNS-42细胞系(人脑胶质瘤细胞冷藏平台)
SW 780[SW-780,SW780]细胞系(人膀胱移行细胞冷藏平台)
HCC-1438细胞系(人肺癌细胞冷藏平台)
NCI-H748细胞系(人肺癌细胞冷藏平台)
CCC-HSF-1细胞系(人皮肤成纤维细胞冷藏平台)
Delapril Hydrochloride
Methyl 5-broMothiazole-4-carboxylate
(R)-(-)-1-Methyl-3-pyrrolidinol, 99%
Thioflavine S, Practical
6-tert-Butyl-2,4-xylenol
KYSE450细胞系(人食管癌细胞冷藏平台)
JurkatE6-1细胞系(人急性T淋巴细胞冷藏平台)
RPMI 6666细胞系(人霍奇金淋巴瘤细胞冷藏平台)
TGBC11TKB细胞系(人胃癌细胞冷藏平台)
AGS细胞系(人胃腺癌细胞冷藏平台)
ACC-M细胞系(人涎腺癌细胞冷藏平台)
BV2细胞系(小鼠小胶质细胞冷藏平台)
HMrSV5细胞系(人腹膜间皮细胞冷藏平台)
SUP-B15细胞系(人Ph+急淋白血病细胞冷藏平台)
U-138MG细胞系(人脑星形胶质母细胞冷藏平台)
COLO-206F细胞系(人结肠癌细胞冷藏平台)
RF952细胞系(人子宫内膜癌细胞冷藏平台)
HSC-T6细胞系(大鼠肝星状细胞冷藏平台)
CHL细胞系(仓鼠肺细胞冷藏平台)
BE(2)M17细胞系(人成神经细胞冷藏平台)
MOPC细胞系(小鼠少突胶质前体细胞冷藏平台)
NCTC clone 929细胞系(小鼠成纤维细胞冷藏平台)
tris(propan-2-yloxy)silane
Copper(I) oxide
Hexadecanedioic acid
GHRL ELISA Kit
UACC-812细胞系(人乳腺导管瘤细胞冷藏平台)
LUDLU-1细胞系(人肺癌鳞癌细胞冷藏平台)
HT-22细胞系(小鼠海马神经元细胞冷藏平台)
SBC-5细胞系(人肺癌细胞冷藏平台)
TE-15细胞系(人食管癌细胞冷藏平台)
Methyl undecanoate, 97%
3-Fluoro-4-methylbenzamide oxime
Z-Lys-OH
(S)-(-)-2-Amino-4-pentenoic acid hydrochloride, 97%
Ferrous oxalate
HCC-1395细胞系(人乳腺癌细胞冷藏平台)
MDA-MB-453细胞系(人乳腺癌细胞冷藏平台)
NCI-H1792[H1792]细胞系(人肺癌细胞冷藏平台)
MDA-MB-157细胞系(人乳腺癌细胞冷藏平台)
G422细胞系(小鼠脑神经胶质母细胞冷藏平台)
H125细胞系(人肺癌细胞冷藏平台)
NBL-S细胞系(人神经母细胞冷藏平台)
Guinea pig ACE (Angiotensin I Converting Enzyme) ELISA Kit
Human Vascular Endothelial cell Growth Factor D,VEGF-D ELISA Kit
Human FGF8 ELISA Kit
NGF ELISA Kit
Rat PKCB1 (Protein Kinase C Beta 1) ELISA Kit
IL1RA ELISA Kit
Human Calretinin,CR ELISA Kit
Human EGR3 (Early Growth Response Protein 3) ELISA Kit
RH-35细胞系(大鼠肝癌细胞冷藏平台)
H3255细胞系(人肺癌细胞冷藏平台)
NCI-H929细胞系(人瘤细胞冷藏平台)
HCCC-9810细胞系(人肝癌细胞冷藏平台)
LC-1sq细胞系(人肺癌鳞癌细胞冷藏平台)
TG-905细胞系(人脑胶质母细胞冷藏平台)
Renca细胞系(小鼠肾癌细胞冷藏平台)
HCC202细胞系(人乳腺原发性导管癌细胞冷藏平台)
HCSMC细胞系(人结肠平滑肌细胞冷藏平台)
Ramos细胞系(人B淋巴瘤细胞冷藏平台)
2-Nitrophenylhydrazine
naphthalene-1-thiol
1-Ethynyl-1-cyclohexanol
IP-1 ELISA Kit
HS-578T细胞系(人乳腺癌细胞冷藏平台)
SW 1573细胞系(人肺泡细胞冷藏平台)
MC3T3-E1细胞系(小鼠胚胎成骨前体细胞冷藏平台)
GOS-3细胞系(人胶质瘤细胞冷藏平台)
NCI-H1435[H1435]细胞系(人肺癌细胞冷藏平台)
1,2,3-Trifluorobenzene, 99%
1-(3-Chloro-4-methylphenyl)hydrazine hydrochloride, 97%
1-(4-Methoxyphenyl)cyclohexanecarboxylic acid
Fmoc-Lys(Mtt)-OH
5-Iodoindan-1-one
MA-c细胞系(小鼠星形胶质细胞冷藏平台)
OV2008细胞系(人卵巢癌细胞冷藏平台)
CL187/CCL187细胞系(人大肠癌细胞冷藏平台)
NCI-H1385细胞系(人肺癌细胞冷藏平台)
Y3-Ag 1.2.3细胞系(大鼠瘤细胞冷藏平台)
MFM-223细胞系(人乳腺癌细胞冷藏平台)
BT-325细胞系(人脑多型胶质母细胞冷藏平台)
DDIT3 ELISA Kit
Human hepatitis B virus X Ag,HBxAg ELISA Kit
Human BCAN (Brevican) ELISA Kit
IL-6 ELISA Kit
IL-1β ELISA Kit
HSP90β1 ELISA Kit
Human CK-LMW (Cytokeratin Low Molecular Weight) ELISA Kit
HJV ELISA Kit
LN229细胞系(人脑胶质细胞冷藏平台)
CCD-33Co细胞系(人结肠成纤维细胞冷藏平台)
MN9D细胞系(小鼠中脑多巴胺能神经元细胞冷藏平台)
HCC70细胞系(人乳腺导管癌细胞冷藏平台)
JK(Jurkat)细胞系(人淋巴细胞冷藏平台)
ECV-304[ECV304,ECV304]细胞系(人脐静脉内皮细胞冷藏平台)
3T6swiss细胞系(小鼠胚胎成纤维细胞冷藏平台)
3-Thien-2-ylbenzaldehyde
Benzonitrile
3-HydroxyMethyl-2-Methylbiphenyl
1-BroMo-4-(Methylsulfinyl)benzene
5-Hydroxy-1-Methyl-3-trifluoroMethyl-1H-pyrazole, 99+%
Malme-3M细胞系(人恶性黑色素瘤细胞冷藏平台)
LX-1细胞系(人肝星形细胞冷藏平台)
Mv1Lu细胞系(貂肺上皮细胞冷藏平台)
EPC细胞系(大鼠血管内皮祖细胞冷藏平台)
CCC-HSF-1细胞系(人皮肤成纤维细胞冷藏平台)
ASC细胞系(人宫颈非典型鳞状细胞冷藏平台)
3T3 L1细胞系(小鼠胚胎成纤维细胞冷藏平台)
4-chloropyrocatechol
5-amino-8-quinolinol
4-Butoxyaniline
trihexyl trimellitate
2,6-Dichlorophenylacetic acid
BV2细胞系(小鼠小胶质细胞冷藏平台)
NCI-BL2141[BL2141]细胞系(人B淋巴细胞冷藏平台)
VLcop细胞系(人前列腺癌细胞冷藏平台)
S180-V细胞系(小鼠腹水瘤细胞冷藏平台)
EC109细胞系(人食管癌细胞冷藏平台)
MFC细胞系(小鼠前胃癌细胞冷藏平台)
HT29细胞系(人结直肠腺癌细胞冷藏平台)
CAL-33细胞系(人舌磷癌细胞冷藏平台)
HPSC细胞系(人星状细胞冷藏平台)
NCI-H1155细胞系(人肺癌细胞冷藏平台)
NCI-H522[H522]细胞系(人肺癌细胞冷藏平台)
4-BroMophenol, 99%
N-Boc-L-aspartic acid 4-benzyl 1-(4-nitrophenyl) ester, 98%
Tri-n-butyl citrate, 99%
4-Iodobenzoic acid
DRG细胞系(大鼠脊髓背角神经细胞冷藏平台)
TPC1细胞系(人甲状腺癌细胞冷藏平台)
NCI-H661[H661]细胞系(人肺癌细胞冷藏平台)
H9C2细胞系(大鼠心肌细胞冷藏平台)
ZRLC-1细胞系(人肺腺癌细胞冷藏平台)
C1498细胞系(小鼠白血病细胞冷藏平台)
Meso-1,4-Dichloro-2,3-butanediol
Ethyl 7-broMo-4-oxo-pyrido[1,2-a]pyriMidine-3-carboxylate
Trifluoroacetic acid, aMMoniuM salt, 98%
Povidone-Iodine, USP
3-Methyloctane
GRSL细胞系(小鼠胸腺性白血病细胞冷藏平台)
LAD2细胞系(人肥大细胞冷藏平台)
HRPTEpiC细胞系(人肾小管上皮细胞冷藏平台)
SW 1088[SW-1088,SW1088]细胞系(人脑星型胶质瘤细胞冷藏平台)
NCI-H446细胞系(人肺癌细胞冷藏平台)
TGW细胞系(人神经母细胞冷藏平台)
H-EMC-SS细胞系(人软骨肉瘤细胞冷藏平台)
VERO C1008细胞系(非洲绿猴肾细胞冷藏平台)
NCI-H810细胞系(人肺癌细胞冷藏平台)
HBEpiC细胞系(人支气管上皮细胞冷藏平台)
VSMC细胞系(大鼠胸主动脉平滑肌细胞冷藏平台)
OCI-LY8细胞系(人B淋巴瘤细胞冷藏平台)
SNU-886细胞系(人肝癌细胞冷藏平台)
SEG1细胞系(人食管腺癌细胞冷藏平台)
FHC细胞系(人正常结直肠粘膜细胞冷藏平台)
NCI-H146细胞系(人肺癌细胞冷藏平台)
NCI-H647细胞系(人肺癌细胞冷藏平台)
Ethylenediamine-N,N'-diacetic acid
2,4'-Dichloroacetophenone
1-chloro-7-fluoroheptane
TNX ELISA Kit
Lu-165细胞系(人肺腺癌细胞冷藏平台)
HGF-1细胞系(人牙龈成纤维细胞冷藏平台)
CHRF细胞系(人巨核细胞冷藏平台)
AML12细胞系(小鼠肝细胞冷藏平台)
SNU-216细胞系(人胃癌细胞冷藏平台)
3-phenyl-1H-pyrazole-5-carboxylic acid(SALTDATA: FREE)
2-(Tributylstannyl)thiazole
Ethyl 4-methyl-4-pentenoate, 95%
Nitrilotris(methylene)triphosphonic acid, 50 wt% solution in water
3,3',4,4'-Biphenyltetracarboxylic acid
CL-1细胞系(人肝细胞冷藏平台)
PAN-1细胞系(人导管上皮癌细胞冷藏平台)
COLO320DM[COLO320DM]细胞系(人结直肠腺癌细胞冷藏平台)
SW 900细胞系(人肺癌细胞冷藏平台)
BEL-7402细胞系(人肝癌细胞冷藏平台)
16HBE细胞系(人支气管上皮样细胞冷藏平台)
TYK-nu细胞系(人卵巢癌细胞冷藏平台)
TX-A2 ELISA Kit
ANGPTL1 ELISA Kit
Human PACAP ELISA Kit
1,3-βD glucosidase ELISA Kit
Rat Cholecystokinin,CCK ELISA Kit
BACE 2 ELISA Kit
ACTN2 ELISA Kit
ANF ELISA Kit
RASMC细胞系(大鼠主动脉平滑肌细胞冷藏平台)
A-431细胞系(人表皮癌细胞冷藏平台)
A20细胞系(小鼠B淋巴瘤细胞冷藏平台)
SW1573细胞系(人肺泡细胞冷藏平台)